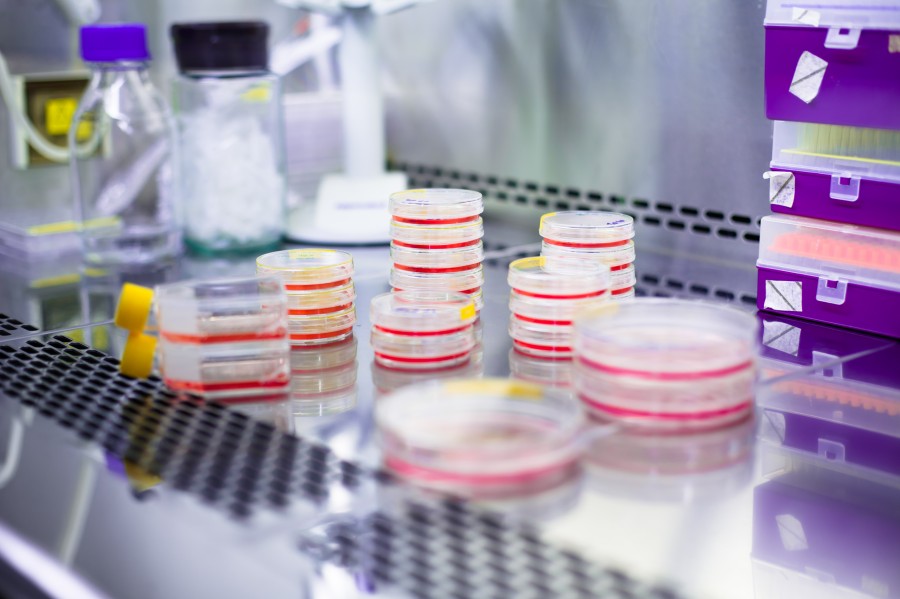
(Protheragen)

Lentiviral Vector Development
InquiryOverview
Obesity is a complex global chronic disease imposing a heavy burden on human health and the global economy. While traditional interventions such as diet, exercise, and medication play a vital role, they often face limitations in long-term adherence and sustained efficacy. Precision gene modification of cells using advanced lentiviral vectors offers a highly promising new pathway. By directly targeting the genetic and metabolic pathways underlying obesity, this technology holds the potential for revolutionary, single-dose, long-acting solutions, bringing renewed hope for sustained weight management and metabolic health.
Precision Gene Delivery Accelerates Progress in Anti-obesity Research
Protheragen specializes in Anti-obesity Therapy Development and provides comprehensive lentiviral vector development services to support research in Gene Therapy, Cell Therapy, and related fields. We engineer potent Gene Delivery Systems specifically designed for anti-obesity therapies, designing and producing high-titer, high-purity lentiviral vectors to precisely deliver targeted genes aimed at modulating metabolic pathways, controlling appetite, or enhancing energy expenditure. Cutting-edge technology ensures the vectors possess safety, efficiency, and efficacy.
Lentiviral Vector Development
- Advanced Plasmid Design
Transfection plasmids are engineered using cutting-edge bioinformatics and molecular biology techniques. We integrate tissue-specific or inducible promoters, optimize codon usage to enhance transgene expression, and incorporate key regulatory elements for efficient packaging and integration.
- Optimized Packaging Cell Lines
Proprietary packaging cell lines are engineered for high-yield lentiviral particle production, ensuring stable and scalable manufacturing processes. These cells undergo rigorous validation to guarantee freedom from foreign pathogens.
- Downstream Processing and Purification
We employ integrated purification techniques, including affinity chromatography and ultracentrifugation, to achieve high-purity, high-concentration lentiviral vectors. The resulting products exhibit reduced impurities and enhanced stability, which is critical for in vivo applications. The ultimately optimized vectors enable efficient gene delivery, ensuring a high proportion of target cells successfully receive therapeutic genes.
Preclinical Studies
Using lentiviral vectors, we efficiently transduce anti-obesity genes—such as those regulating energy metabolism, suppressing appetite, or promoting lipolysis—into preadipocytes or stem cells. Subsequently, we conduct in vitro functional assessments of these genetically modified cells and transplant them back into obesity models to evaluate their long-term efficacy in reducing body weight, improving insulin sensitivity, and even inducing brown fat formation.
Workflow
Our lentiviral vector development service is executed through a highly efficient, precise, and streamlined multi-stage process. We implement comprehensive, systematic oversight throughout the entire workflow—from initial vector design concepts and construction to the final manufacturing and delivery of high-quality products. This end-to-end management model ensures exceptional efficiency and consistency at every critical project milestone.
Gene Synthesis and Plasmid Construction
This process includes integration of specific promoters (e.g., adipose tissue-specific, liver-specific promoters) and any regulatory elements relevant to anti-obesity therapies. Based on the target gene sequence and other information provided by the client, we synthesize the gene and construct a transfer plasmid carrying the target sequence.
High-titer Lentivirus Production
Leveraging a robust, scalable production platform, we generate high-quality lentiviral particles. This involves co-transfecting the constructed transfer plasmid with packaging plasmids into high-yield expression cell lines. Cells are cultured under stringent conditions to maximize viral particle production.
Purification and Quality Control
Following multi-step purification to remove cellular debris and impurities, and subsequent concentration, we conduct comprehensive quality control testing. This includes, but is not limited to, titer determination, sterility testing, mycoplasma testing, and endotoxin testing. This process ensures the safety, efficacy, and purity of the final product.
R&D Support
We also support functional testing in relevant cell lines (e.g., adipocytes, hepatocytes) and obesity animal models to evaluate their potential.

Applications
Utilizing lentiviral vectors to overexpress or knock down specific genes in relevant cell types or animal models to validate novel therapeutic targets for anti-obesity drugs.
Employing lentiviral vectors for gene editing to establish stable cell lines for high-throughput screening, anti-obesity drug discovery, and functional studies of related genes.
Employing lentiviral vectors for gene editing to investigate physiological and pathological changes in models, thereby supporting the development of effective anti-obesity therapies.
Advantages
Exceptional Titers and Purity
Our lentiviral vectors consistently maintain industry-leading high titers and exceptional purity, enabling efficient and long-lasting stable gene expression across a wide range of cell types.
Customized Obesity Targeting
Our core strength is in creating highly specific vectors that precisely target key cell populations. This allows for customized gene expression within tissues like adipose tissue and stem cells, enabling a tailored and effective strategy for obesity research.
End-to-end Support
Beyond vector production, we offer end-to-end support spanning gene design consultation to post-delivery functional assessment guidance, accelerating project progress.
Beyond lentiviral vector development, we offer comprehensive testing and analysis services that delve into the complexity of obesity from multiple dimensions. These services provide critical data to accelerate your research, enabling more effective exploration of obesity's underlying mechanisms, disease risks, and scientifically grounded weight management strategies.

Publication Data
Title: Gene therapy based on mesenchymal stem cells derived from adipose tissue for the treatment of obesity and its metabolic complications
Journal: International Journal of Molecular Sciences, 2023
DOI: https://doi.org/10.3390/ijms24087468
Summary: This paper introduces several fat-focused anti-obesity cell therapies and gene therapies. Among them, anti-obesity therapies based on adipose-derived mesenchymal stem cells (ADMSCs) represent a promising therapeutic strategy. To generate ADMSCs with enhanced functionality and therapeutic potential, researchers employ gene modification techniques such as viral transduction using vectors like lentivirus and adenovirus, as well as non-viral transduction. Research indicates that enhancing distinct properties of ADMSCs—such as proliferation or differentiation—can improve their therapeutic efficacy and demonstrate strong potential for treating obesity.
Customer Review
High-Quality Product Delivery
"Protheragen's lentiviral vectors demonstrate exceptionally high infection efficiency and transduction titers. This stable integration capability has successfully enabled us to rapidly establish stable gene expression cell lines for high-throughput screening, significantly accelerating the efficiency of our early-stage drug target validation."— K*, Manager of Operations and Procurement
Excellent Technical Support
"The Protheragen team possesses extensive expertise in designing complex multi-gene expression constructs. When we encountered fluctuations in transduction efficiency during our project, their technical specialists promptly intervened and provided critical optimization strategies. This experience underscored that their service represents genuine technical collaboration, not merely product delivery."— J*, Laboratory Manager
Frequently Asked Questions
-
How do you ensure the purity and quality of lentiviral vectors?
We employ advanced purification techniques such as chromatography and implement stringent quality control measures. Each batch undergoes comprehensive testing for titer, sterility, endotoxin levels, etc., to ensure high-quality products suitable for preclinical research.
-
Can you provide production solutions at different scales for anti-obesity research?
Absolutely! We offer flexible production scales, ranging from small research-grade batches suitable for in vitro studies to large-volume preclinical production meeting the demands of extensive in vivo animal models. Please feel free to share your specific requirements.
-
Do you provide experimental design support for vector application in anti-obesity models?
Absolutely. Our team possesses extensive experience in obesity model-based research and can offer experimental design consultation. We assist in planning efficient in vitro and in vivo research protocols to evaluate your anti-obesity therapies.
Protheragen stands as a trusted partner in advancing the development of anti-obesity therapies through our lentiviral vector development services. Combining years of scientific expertise with high-end manufacturing capabilities, we are committed to delivering high-quality, cutting-edge technology and comprehensive support to ensure efficient project progression. To learn how our lentiviral vector development services accelerate your anti-obesity therapy project, please do not hesitate to contact us.
Reference
- Lopez-Yus, M.; et al. Gene therapy based on mesenchymal stem cells derived from adipose tissue for the treatment of obesity and its metabolic complications. International Journal of Molecular Sciences. 2023, 24(8): 7468. (CC BY 4.0)
All of our services and products are intended for preclinical research use only and cannot be used to diagnose, treat or manage patients.